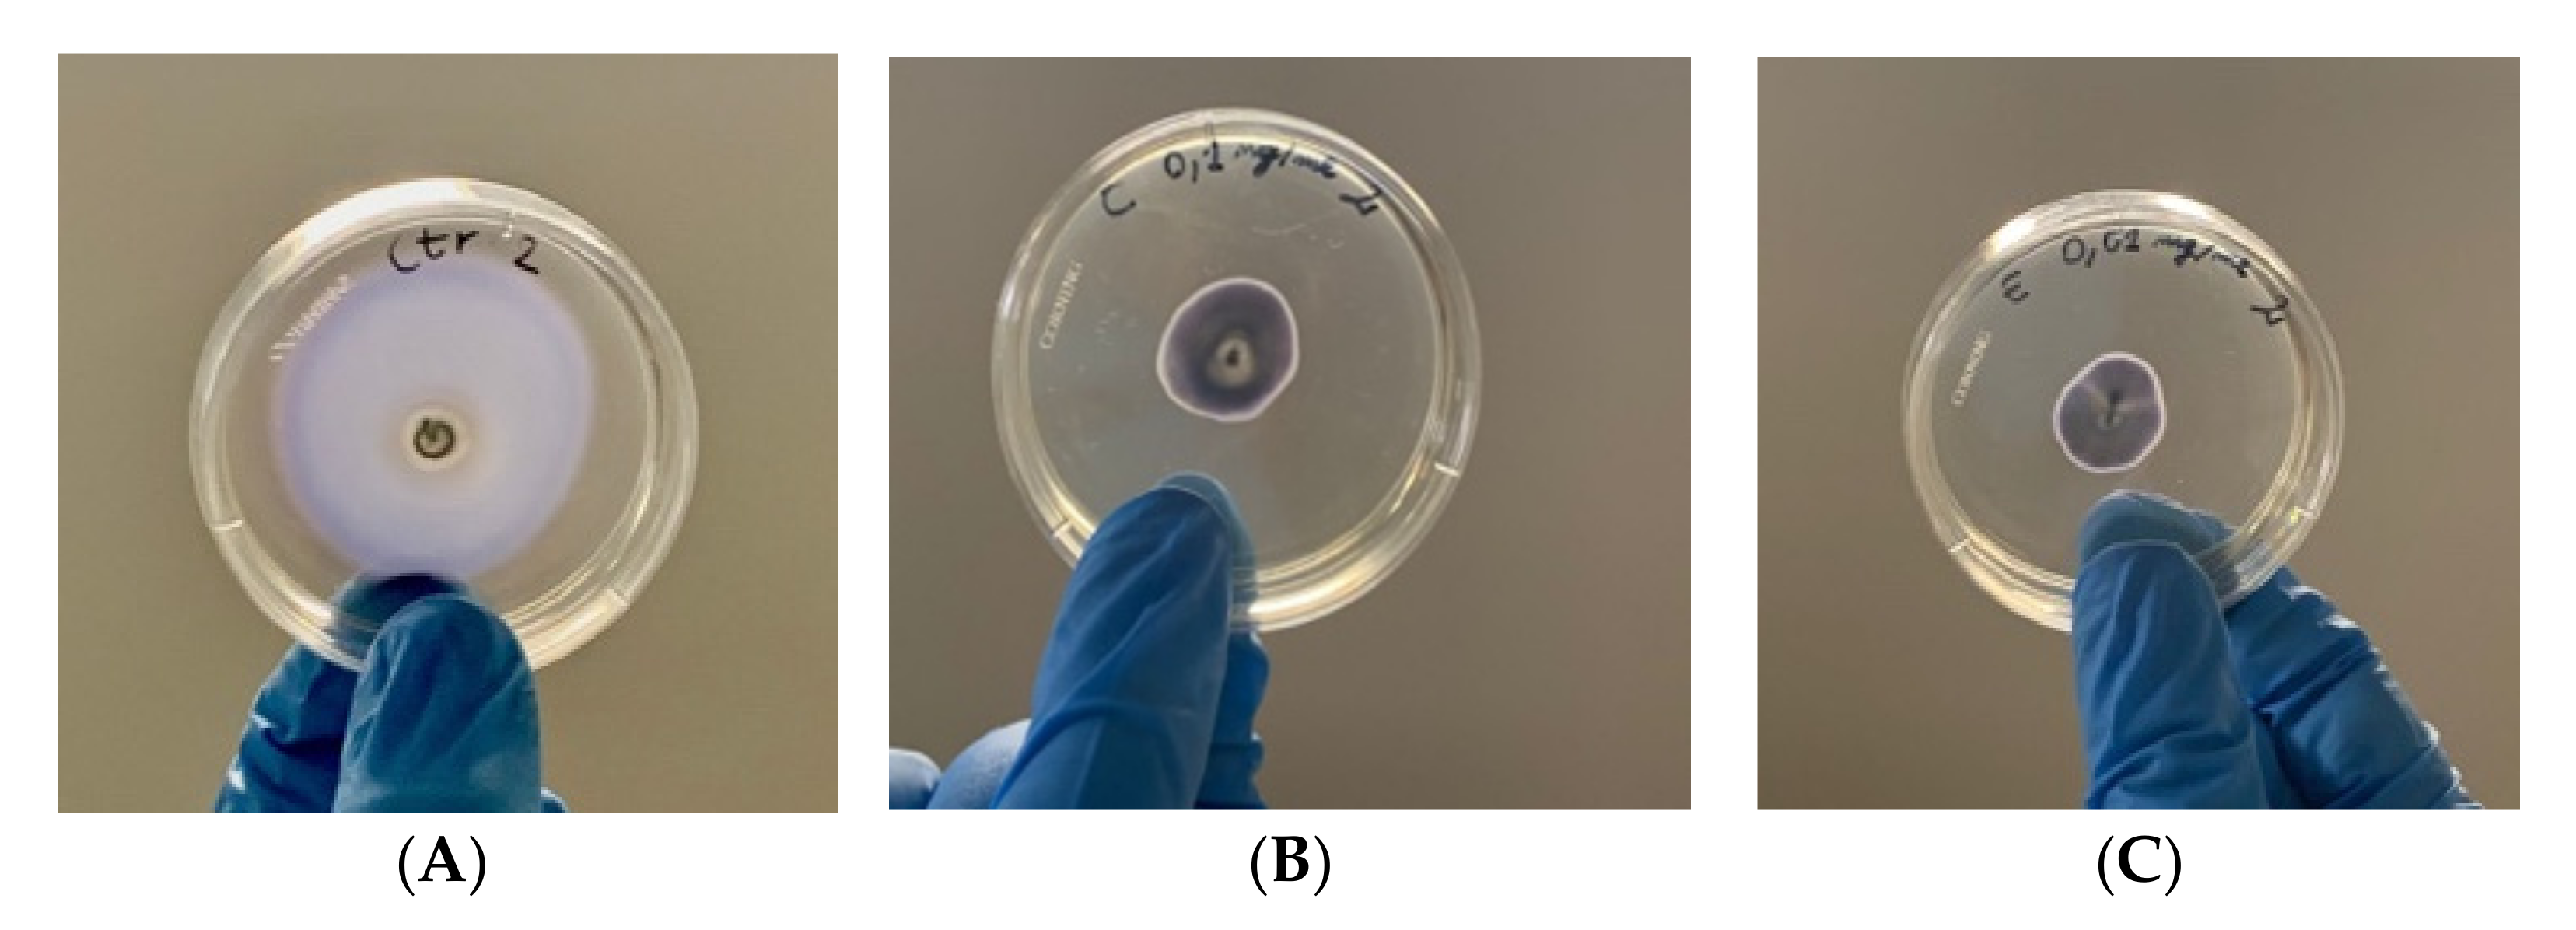

Control of Erwinia amylovora Growth by Moringa oleifera Leaf Extracts: In Vitro and in Planta Effects
Abstract
:1. Introduction
2. Results
2.1. Determination of MICs of MOEs
2.2. In Vitro Assessment of Membrane Permeability Alteration
2.3. In Vitro Assessment of Bacterial Swarming
2.4. In Vitro Assessment of Biofilm Formation
2.5. In Vitro Assessment of Amylovoran Production
2.6. Antimicrobial Effects on Apple Trees
3. Discussion
Focus on Virulence Factors and Amylovoran Production
4. Materials and Methods
4.1. Erwinia amylovora Strains and Culture Conditions
4.2. Determination of the Minimum Inhibitory Concentration (MIC) of Different M. oleifera Lam. Extracts
4.3. Membrane Permeability Assay
4.4. Swarming Motility Assay
4.5. Biofilm Formation
4.6. Amylovoran Production
4.7. Effects of MOE on Apple Trees
4.8. Plant Material and Extraction Methods
- -
- Hydroalcoholic extract (HA-MOE): Leaf powder was mixed with hydroalcoholic solution (ethanol:water, 70:30) at room temperature, filtered and concentrated in vacuum.
- -
- Methanolic extract (MeOH-MOE): Leaf powder was mixed with methanol and subjected to two sonication cycles (40 °C, 60 min, 80%) with subsequent centrifugation and concentrated under vacuum.
- -
- Decoction (In-MOE): Leaf powder was left to infuse for 30 min with 150 mL of de- ionized water, previously brought to a boil. The decoction solution was filtered and lyophilized.
- -
- Water extract with maltodextrins (WMD-MOE): Dried leaves were extracted with water (raw material:solvent 1:10) for 45 min at 65 °C. After filtration, concentration and pasteurization, the extract was spray dried using maltodextrin, obtaining a fine powder.
- -
- Hydroalcoholic extract with maltodextrins (HAMD-MOE): Dried leaves were extracted with 50% ethanol (raw material:solvent 1:10) for 45 min at 45 °C. After filtration, concentration and pasteurization, the extract was spray dried using maltodextrin, obtaining a fine powder.
4.9. Statistical Analysis
5. Conclusions
Author Contributions
Funding
Institutional Review Board Statement
Data Availability Statement
Acknowledgments
Conflicts of Interest
References
- Kharadi, R.R.; Sundin, G.W. Dissecting the process of xylem colonization through biofilm formation in Erwinia amylovora. J. Plant Pathol. 2021, 103, 41–49. [Google Scholar] [CrossRef]
- Zeng, Q.; Puławska, J.; Schachterle, J. Early events in fire blight infection and pathogenesis of Erwinia amylovora. J. Plant Pathol. 2021, 103, 13–24. [Google Scholar] [CrossRef]
- Slack, S.M.; Zeng, Q.; Outwater, C.A.; Sundin, G.W. Microbiological Examination of Erwinia amylovora Exopolysaccharide Ooze. Phytopathology 2017, 107, 403–411. [Google Scholar] [CrossRef] [Green Version]
- Piqué, N.; Miñana-Galbis, D.; Merino, S.; Tomás, J.M. Virulence Factors of Erwinia amylovora: A Review. Int. J. Mol. Sci. 2015, 16, 12836–12854. [Google Scholar] [CrossRef] [PubMed] [Green Version]
- Yuan, X.; McGhee, G.C.; Slack, S.M.; Sundin, G.W. A Novel Signaling Pathway Connects Thiamine Biosynthesis, Bacterial Respiration, and Production of the Exopolysaccharide Amylovoran in Erwinia amylovora. Mol. Plant-Microbe Interact. 2021, 34, 1193–1208. [Google Scholar] [CrossRef]
- Mendes, R.; Regalado, L.; Luz, J.; Tassi, N.; Teixeira, C.; Gomes, P.; Tavares, F.; Santos, C. In Vitro Evaluation of Five Antimicrobial Peptides against the Plant Pathogen Erwinia amylovora. Biomolecules 2021, 11, 554. [Google Scholar] [CrossRef]
- Gusberti, M.; Klemm, U.; Meier, M.S.; Maurhofer, M.; Hunger-Glaser, I. Fire Blight Control: The Struggle Goes On. A Comparison of Different Fire Blight Control Methods in Switzerland with Respect to Biosafety, Efficacy and Durability. Int. J. Environ. Res. Public Health 2015, 12, 11422–11447. [Google Scholar] [CrossRef] [Green Version]
- Ivanović, M.; Gašić, K.; Prokić, A.; Kuzmanović, N.; Zlatković, N.; Obradovic, A. Screening for copper and antibiotic resistance in Erwinia amylovora population from Serbia. Acta Hortic. 2016, 1139, 715–720. [Google Scholar] [CrossRef]
- Smith, D.D.N.; Williams, A.N.; Verrett, J.N.; Bergbusch, N.T.; Manning, V.; Trippe, K.; Stavrinides, J. Resistance to Two Vinylglycine Antibiotic Analogs Is Conferred by Inactivation of Two Separate Amino Acid Transporters in Erwinia amylovora. J. Bacteriol. 2019, 201, e00658-18. [Google Scholar] [CrossRef] [Green Version]
- Mikiciński, A.; Puławska, J.; Molzhigitova, A.; Sobiczewski, P. Bacterial species recognized for the first time for its biocontrol activity against fire blight (Erwinia amylovora). Eur. J. Plant Pathol. 2019, 156, 257–272. [Google Scholar] [CrossRef] [Green Version]
- Buttimer, C.; McAuliffe, O.; Ross, R.P.; Hill, C.; O’Mahony, J.; Coffey, A. Bacteriophages and Bacterial Plant Diseases. Front. Microbiol. 2017, 8, 34. [Google Scholar] [CrossRef] [PubMed] [Green Version]
- Nazzaro, F.; Fratianni, F.; De Martino, L.; Coppola, R.; De Feo, V. Effect of Essential Oils on Pathogenic Bacteria. Pharmaceuticals 2013, 6, 1451–1474. [Google Scholar] [CrossRef] [PubMed]
- Abdalla, A.M.; Alwasilah, H.Y.; Al, R.; Mahjoub, H.; Mohammed, I.; Yagoub, M. Evaluation of Antimicrobial Activity of Moringa oleifera Leaf Ex-Tracts against Pathogenic Bacteria Isolated from Urinary Tract Infected Patients. J. Adv. Lab. Res. Biol. 2016, 7, 47–51. [Google Scholar]
- Pal, S.K.; Mukherjee, P.K.; Saha, K.; Pal, M.; Saha, B.P. Ancient Science of Life. Anc. Sci. Life 1995, 3, 197–199. [Google Scholar]
- Ervianingsih; Mursyid, M.; Annisa, R.N.; Zahran, I.; Langkong, J.; Kamaruddin, I. Antimicrobial activity of moringa leaf (Moringa oleifera L.) extract against the growth of Staphylococcus epidermidis. In IOP Conference Series: Earth and Environmental Science; IOP Publishing: Bristol, UK, 2019; Volume 343, p. 012145. [Google Scholar] [CrossRef]
- Rani, N.Z.A.; Husain, K.; Kumolosasi, E. Moringa Genus: A Review of Phytochemistry and Pharmacology. Front. Pharmacol. 2018, 9, 108. [Google Scholar] [CrossRef] [Green Version]
- Sreelatha, S.; Padma, P.R. Antioxidant Activity and Total Phenolic Content of Moringa oleifera Leaves in Two Stages of Maturity. Mater. Veg. 2009, 64, 303–311. [Google Scholar] [CrossRef]
- Atawodi, S.E.; Atawodi, J.C.; Idakwo, G.A.; Pfundstein, B.; Haubner, R.; Wurtele, G.; Bartsch, H.; Owen, R.W. Evaluation of the Polyphenol Content and Antioxidant Properties of Methanol Extracts of the Leaves, Stem, and Root Barks of Moringa oleifera Lam. J. Med. Food 2010, 13, 710–716. [Google Scholar] [CrossRef]
- Dhakad, A.K.; Ikram, M.; Sharma, S.; Khan, S.; Pandey, V.V.; Singh, A. Biological, nutritional, and therapeutic significance of Moringa oleifera Lam. Phytother. Res. 2019, 33, 2870–2903. [Google Scholar] [CrossRef]
- Leone, A.; Fiorillo, G.; Criscuoli, F.; Ravasenghi, S.; Santagostini, L.; Fico, G.; Spadafranca, A.; Battezzati, A.; Schiraldi, A.; Pozzi, F.; et al. Nutritional Characterization and Phenolic Profiling of Moringa oleifera Leaves Grown in Chad, Sahrawi Refugee Camps, and Haiti. Int. J. Mol. Sci. 2015, 16, 18923–18937. [Google Scholar] [CrossRef] [Green Version]
- Sahakitpichan, P.; Mahidol, C.; Disadee, W.; Ruchirawat, S.; Kanchanapoom, T. Unusual glycosides of pyrrole alkaloid and 4′-hydroxyphenylethanamide from leaves of Moringa oleifera. Phytochemistry 2011, 72, 791–795. [Google Scholar] [CrossRef]
- Chhikara, N.; Kaur, A.; Mann, S.; Garg, M.; Sofi, S.A.; Panghal, A. Bioactive compounds, associated health benefits and safety considerations of Moringa oleifera L.: An updated review. Nutr. Food Sci. 2020, 51, 255–277. [Google Scholar] [CrossRef]
- Elgamily, H.; Moussa, A.; Elboraey, A.; El-Sayed, H.; Al-Moghazy, M.; Abdalla, A. Microbiological Assessment of Moringa oleifera Extracts and Its Incorporation in Novel Dental Remedies against Some Oral Pathogens. Open Access Maced. J. Med Sci. 2016, 4, 585–590. [Google Scholar] [CrossRef] [PubMed] [Green Version]
- Fontana, R.; Caproni, A.; Buzzi, R.; Sicurella, M.; Buratto, M.; Salvatori, F.; Pappadà, M.; Manfredini, S.; Baldisserotto, A.; Marconi, P. Effects of Moringa oleifera Leaf Extracts on Xanthomonas campestris pv. campestris. Microorganisms 2021, 9, 2244. [Google Scholar] [CrossRef] [PubMed]
- Baldisserotto, A.; Buso, P.; Radice, M.; Dissette, V.; Lampronti, I.; Gambari, R.; Manfredini, S.; Vertuani, S. Moringa oleifera Leaf Extracts as Multifunctional Ingredients for “Natural and Organic” Sunscreens and Photoprotective Preparations. Molecules 2018, 23, 664. [Google Scholar] [CrossRef] [PubMed] [Green Version]
- Zhao, Y.; Wang, D.; Nakka, S.; Sundin, G.W.; Korban, S.S. Systems level analysis of two-component signal transduction systems in Erwinia amylovora: Role in virulence, regulation of amylovoran biosynthesis and swarming motility. BMC Genom. 2009, 10, 245. [Google Scholar] [CrossRef] [PubMed] [Green Version]
- Mickymaray, S. Efficacy and Mechanism of Traditional Medicinal Plants and Bioactive Compounds against Clinically Important Pathogens. Antibiotics 2019, 8, 257. [Google Scholar] [CrossRef] [PubMed] [Green Version]
- Yang, F.; Korban, S.S.; Pusey, P.L.; Elofsson, M.; Sundin, G.W.; Zhao, Y. Small-molecule inhibitors suppress the expression of both typeIIIsecretion and amylovoran biosynthesis genes in Erwinia amylovora. Mol. Plant Pathol. 2014, 15, 44–57. [Google Scholar] [CrossRef]
- Khokhani, D.; Zhang, C.; Li, Y.; Wang, Q.; Zeng, Q.; Yamazaki, A.; Hutchins, W.; Zhou, S.-S.; Chen, X.; Yang, C.-H. Discovery of Plant Phenolic Compounds That Act as Type III Secretion System Inhibitors or Inducers of the Fire Blight Pathogen, Erwinia amylovora. Appl. Environ. Microbiol. 2013, 79, 5424–5436. [Google Scholar] [CrossRef] [Green Version]
- Ozrenk, K.; Balta, F.; Çelik, F. Levels of fire blight (Erwinia amylovora) susceptibility of native apple, pear and quince germplasm from Lake Van Basin, Turkey. Eur. J. Plant Pathol. 2011, 132, 229–236. [Google Scholar] [CrossRef]
- Harsha, P.S.S.; Lavelli, V. Effects of Maltodextrins on the Kinetics of Lycopene and Chlorogenic Acid Degradation in Dried Tomato. Molecules 2019, 24, 1042. [Google Scholar] [CrossRef] [Green Version]
- Pettinato, M.; Aliakbarian, B.; Casazza, A.; Perego, P. Encapsulation of antioxidants from spent coffee ground extracts by spray drying. Chem. Eng. Trans. 2017, 57, 1219–1224. [Google Scholar]
- Cowan, M.M. Plant Products as Antimicrobial Agents. Clin. Microbiol. Rev. 1999, 12, 564–582. [Google Scholar] [CrossRef] [PubMed] [Green Version]
- Cushnie, T.P.T.; Lamb, A.J. Antimicrobial activity of flavonoids. Int. J. Antimicrob. Agents 2005, 26, 343–356. [Google Scholar] [CrossRef]
- Ikigai, H.; Nakae, T.; Hara, Y.; Shimamura, T. Bactericidal catechins damage the lipid bilayer. Biochim. Biophys. Acta—Biomembr. 1993, 1147, 132–136. [Google Scholar] [CrossRef]
- Griep, M.A.; Blood, S.; Larson, M.; Koepsell, S.A.; Hinrichs, S.H. Myricetin inhibits Escherichia coli DnaB helicase but not primase. Bioorgan. Med. Chem. 2007, 15, 7203–7208. [Google Scholar] [CrossRef] [PubMed] [Green Version]
- Liu, J.; Du, C.; Beaman, H.T.; Monroe, M.B.B. Characterization of Phenolic Acid Antimicrobial and Antioxidant Structure-Property Relationships. Pharmaceutics 2020, 12, 419. [Google Scholar] [CrossRef]
- Hossain, S.I.; Saha, S.C.; Deplazes, E. Phenolic compounds alter the ion permeability of phospholipid bilayers via specific lipid interactions. Phys. Chem. Chem. Phys. 2021, 23, 22352–22366. [Google Scholar] [CrossRef]
- Burt, S. Essential oils: Their antibacterial properties and potential applications in foods—A review. Int. J. Food Microbiol. 2004, 94, 223–253. [Google Scholar] [CrossRef]
- Marrufo, T.; Nazzaro, F.; Mancini, E.; Fratianni, F.; Coppola, R.; De Martino, L.; Agostinho, A.B.; De Feo, V. Chemical Composition and Biological Activity of the Essential Oil from Leaves of Moringa oleifera Lam. Cultivated in Mozambique. Molecules 2013, 18, 10989–11000. [Google Scholar] [CrossRef] [Green Version]
- Scalbert, A. Antimicrobial properties of tannins. Phytochemistry 1991, 30, 3875–3883. [Google Scholar] [CrossRef]
- Cushnie, T.T.; Cushnie, B.; Lamb, A. Alkaloids: An overview of their antibacterial, antibiotic-enhancing and antivirulence activities. Int. J. Antimicrob. Agents 2014, 44, 377–386. [Google Scholar] [CrossRef] [PubMed]
- Muñoz-Cazares, N.; García-Contreras, R.; Pérez-López, M.; Castillo-Juárez, I. Phenolic compounds with anti-virulence properties. In Phenolic Compounds—Biological Activity; Soto-Hernandez, M., Palma-Tenango, M., del Rosario Garcia-Mateos, M., Eds.; InTechOpen: Rijeka, Croatia, 2017; Volume 8, pp. 139–167. [Google Scholar] [CrossRef] [Green Version]
- Tsuchiya, H.; Sato, M.; Miyazaki, T.; Fujiwara, S.; Tanigaki, S.; Ohyama, M.; Tanaka, T.; Iinuma, M. Comparative study on the antibacterial activity of phytochemical flavanones against methicil-lin-resistant Staphylococcus aureus. J. Ethnopharmacol. 1996, 50, 27–34. [Google Scholar] [CrossRef]
- Akhlaghi, M.; Tarighi, S.; Taheri, P. Effects of plant essential oils on growth and virulence factors of Erwinia amylovora. J. Plant Pathol. 2019, 102, 409–419. [Google Scholar] [CrossRef]
- Koczan, J.M.; McGrath, M.J.; Zhao, Y.; Sundin, G.W. Contribution of Erwinia amylovora Exopolysaccharides Amylovoran and Levan to Biofilm Formation: Implications in Pathogenicity. Phytopathol. 2009, 99, 1237–1244. [Google Scholar] [CrossRef] [PubMed] [Green Version]
- Sahebi, M.; Tarighi, S.; Taheri, P. The Arac-like transcriptional regulator YqhC is involved in pathogenicity of Erwinia amylovora. J. Appl. Microbiol. 2021, 132, 1319–1329. [Google Scholar] [CrossRef] [PubMed]
- Borruso, L.; Salomone-Stagni, M.; Polsinelli, I.; Schmitt, A.; Benini, S. Conservation of Erwinia amylovora pathogenicity-relevant genes among Erwinia genomes. Arch. Microbiol. 2017, 199, 1335–1344. [Google Scholar] [CrossRef] [Green Version]
- Bellemann, P.; Bereswill, S.; Berger, S.; Geider, K. Visualization of capsule formation by Erwinia amylovora and assays to determine amylovoran synthesis. Int. J. Biol. Macromol. 1994, 16, 290–296. [Google Scholar] [CrossRef]
- Santander, R.D.; Biosca, E.G. Erwinia amylovorapsychrotrophic adaptations: Evidence of pathogenic potential and survival at temperate and low environmental temperatures. PeerJ 2017, 5, e3931. [Google Scholar] [CrossRef] [Green Version]
- Ordax, M.; Marco-Noales, E.; López, M.M.; Biosca, E.G. Survival Strategy of Erwinia amylovora against Copper: Induction of the Viable-but-Nonculturable State. Appl. Environ. Microbiol. 2006, 72, 3482–3488. [Google Scholar] [CrossRef] [Green Version]
- Crowley, L.C.; Scott, A.P.; Marfell, B.J.; Boughaba, J.A.; Chojnowski, G.; Waterhouse, N.J. Measuring Cell Death by Propidium Iodide Uptake and Flow Cytometry. Cold Spring Harb. Protoc. 2016, 2016. [Google Scholar] [CrossRef]
- Chen, W.; Mani, S.; Tang, J.X. An Inexpensive Imaging Platform to Record and Quantitate Bacterial Swarming. Bio-Protocol 2021, 11, e4162. [Google Scholar] [CrossRef] [PubMed]
- Schindelin, J.; Arganda-Carreras, I.; Frise, E.; Kaynig, V.; Longair, M.; Pietzsch, T.; Preibisch, S.; Rueden, C.; Saalfeld, S.; Schmid, B.; et al. Fiji: An open-source platform for biological-image analysis. Nat. Methods 2012, 9, 676–682. [Google Scholar] [CrossRef] [PubMed] [Green Version]
- Wilson, C.; Lukowicz, R.; Merchant, S.; Valquier-Flynn, H.; Caballero, J.; Sandoval, J.; Okuom, M.; Huber, C.; Brooks, T.D.; Wilson, E.; et al. Quantitative and Qualitative Assessment Methods for Biofilm Growth: A Mini-review. Res. Rev. J. Eng. Technol. 2017, 6. [Google Scholar]

| M. oleifera Lam. Leaves Extract | MIC (mg/mL) |
|---|---|
| Infusion (In-MOE) | >2 |
| Hydroalcoholic extract (HA-MOE) | 1 |
| Methanolic extract (MeOH-MOE) | 1 |
| Water extract with maltodextrins (WMD-MOE) | >2 |
| Hydroalcoholic extract with maltodextrins (HAMD-MOE) | 1 |
| BACTERIA | Sample ID | Host | Province of Isolation | Year of Isolation |
|---|---|---|---|---|
| Erwinia amylovora | 49536 | Apple tree | Forlì-Cesena | 2018 |
| Erwinia amylovora | 49540 | Apple tree | Reggio Emilia | 2018 |
| Erwinia amylovora | 50163 | Apple tree | Ravenna | 2018 |
| Erwinia amylovora | 50340 | Apple tree | Ravenna | 2018 |
| Erwinia amylovora | 50535 | Pear tree | Piacenza | 2018 |
| Erwinia amylovora | 51198 | Pear tree | Ravenna | 2018 |
| Erwinia amylovora | 51201 | Pear tree | Ravenna | 2018 |
| Erwinia amylovora | 51431 | Pear tree | Piacenza | 2018 |
| Erwinia amylovora | 51657 | Pear tree | Ravenna | 2018 |
| Erwinia amylovora | 52140 | Apple tree | Bologna | 2018 |
| Erwinia amylovora | 52458 | Pear tree | Ferrara | 2018 |
| Erwinia amylovora | 30165 | Pear tree | DSMZ | Before 22 August 1990 |
Publisher’s Note: MDPI stays neutral with regard to jurisdictional claims in published maps and institutional affiliations. |
© 2022 by the authors. Licensee MDPI, Basel, Switzerland. This article is an open access article distributed under the terms and conditions of the Creative Commons Attribution (CC BY) license (https://creativecommons.org/licenses/by/4.0/).
Share and Cite
Fontana, R.; Macchi, G.; Caproni, A.; Sicurella, M.; Buratto, M.; Salvatori, F.; Pappadà, M.; Manfredini, S.; Baldisserotto, A.; Marconi, P. Control of Erwinia amylovora Growth by Moringa oleifera Leaf Extracts: In Vitro and in Planta Effects. Plants 2022, 11, 957. https://doi.org/10.3390/plants11070957
Fontana R, Macchi G, Caproni A, Sicurella M, Buratto M, Salvatori F, Pappadà M, Manfredini S, Baldisserotto A, Marconi P. Control of Erwinia amylovora Growth by Moringa oleifera Leaf Extracts: In Vitro and in Planta Effects. Plants. 2022; 11(7):957. https://doi.org/10.3390/plants11070957
Chicago/Turabian StyleFontana, Riccardo, Giovanna Macchi, Anna Caproni, Mariaconcetta Sicurella, Mattia Buratto, Francesca Salvatori, Mariangela Pappadà, Stefano Manfredini, Anna Baldisserotto, and Peggy Marconi. 2022. "Control of Erwinia amylovora Growth by Moringa oleifera Leaf Extracts: In Vitro and in Planta Effects" Plants 11, no. 7: 957. https://doi.org/10.3390/plants11070957
APA StyleFontana, R., Macchi, G., Caproni, A., Sicurella, M., Buratto, M., Salvatori, F., Pappadà, M., Manfredini, S., Baldisserotto, A., & Marconi, P. (2022). Control of Erwinia amylovora Growth by Moringa oleifera Leaf Extracts: In Vitro and in Planta Effects. Plants, 11(7), 957. https://doi.org/10.3390/plants11070957

